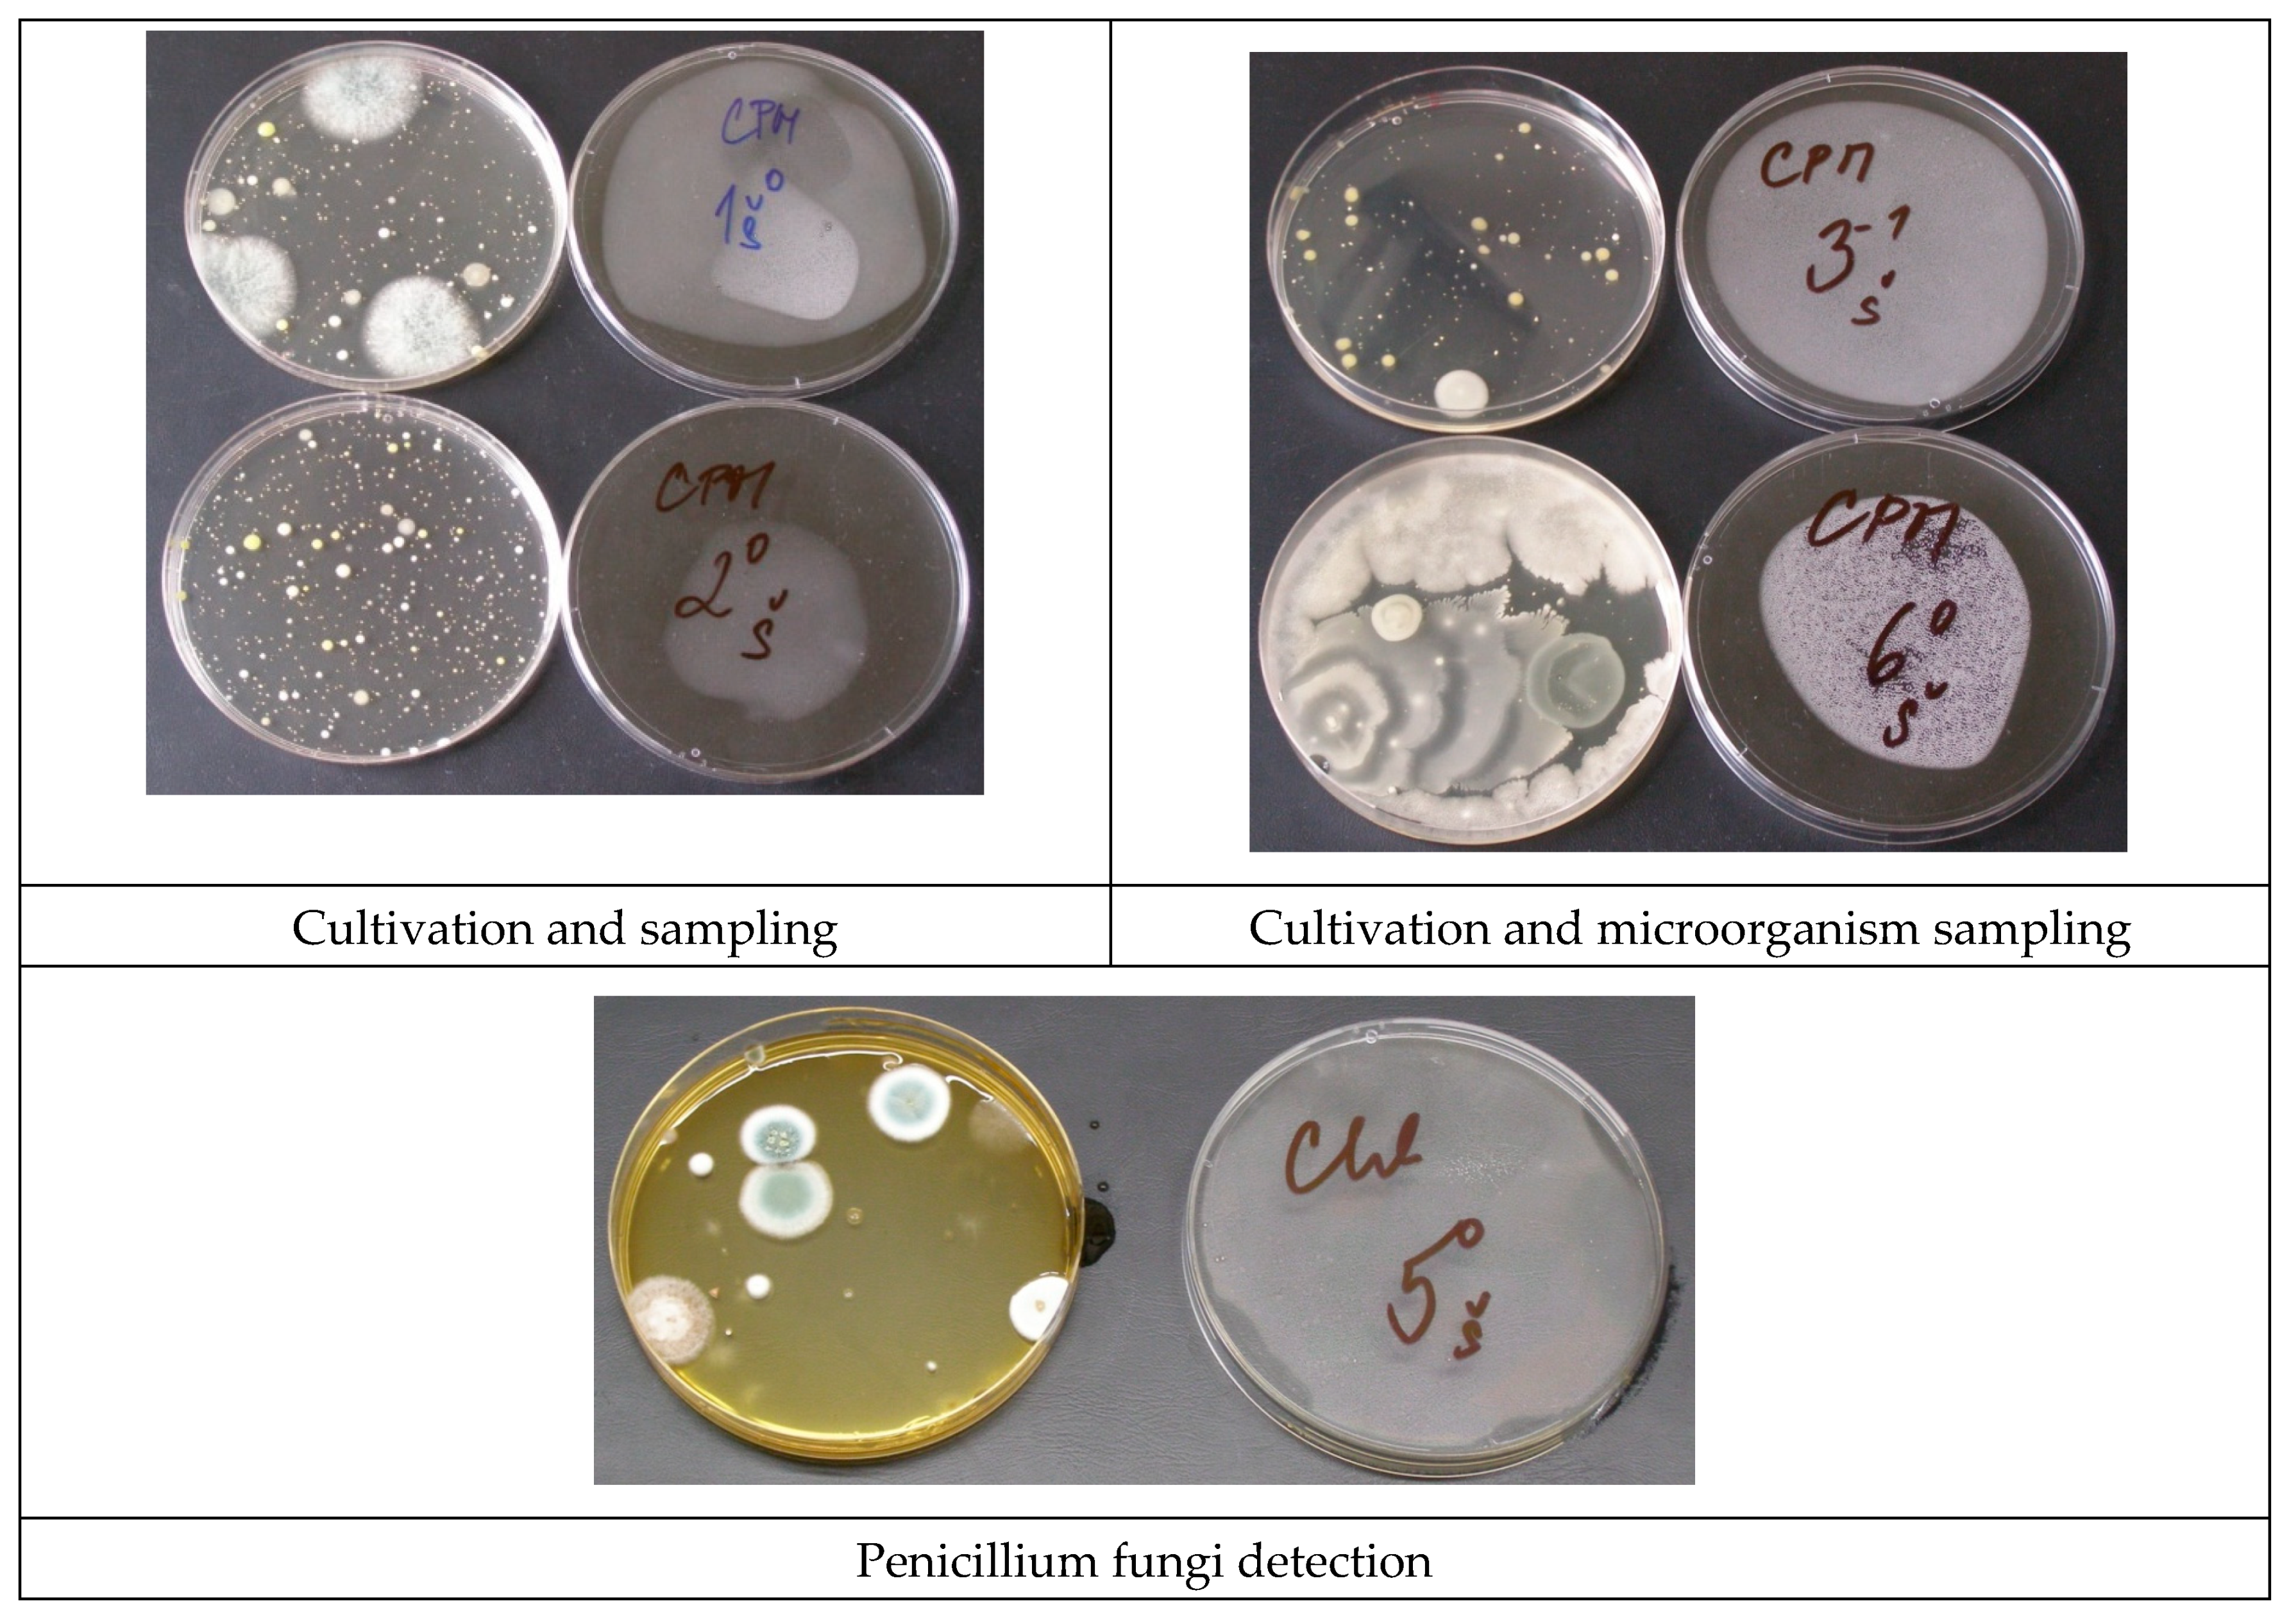
Energies 14 02827 g011 Energies 14 02827 g011

Indoor Climate Performance in a Renovated School Building
Abstract
1. Introduction
2. Methods
2.1. School Building Performance
2.2. Monitoring of CO2 Concentration
- -
- For an outdoor air ventilation rate of 8 to 9 L/s/person, the CO2 level corresponds to around 1000 ppm under steady state conditions (depending on the ventilation system);
- -
- An outdoor air supply rate of 5 L/s/person corresponds to around 1500 ppm under steady state conditions.
2.3. Microbial Testing
3. Results and Discussion
3.1. Results of Monitoring of CO2 Concentration
- The former classroom, occupancy of 26 students and 2 teachers, air volume per person of 4.68 m3, natural ventilation, window opening depending on the teacher’s decision and clear sky conditions (Figure 6) (2 March, 7:00–13:20);
- The former classroom, occupancy of 26 students and 2 teachers, air volume per person of 4.68 m3, natural ventilation, controlled window openings and clear sky conditions (Figure 7) (3 March, 7:20–12:30);
- The renovated classroom, occupancy of 21 students and 2 teachers, air volume per person of 5.7 m3, natural ventilation and window opening depending on the teacher’s decision (Figure 8) (30 November, 7:35–12:50);
- The renovated classroom, occupancy of 21 students and 2 teachers, air volume per person of 5.7 m3, natural ventilation and controlled window openings (Figure 9)_ (1 December, 7:30–12:35).
- -
- Firstly, the classroom ventilation was based on the thermal comfort of the teacher. It was found that the teacher controlled the air change in the classroom by opening the window. Seemingly, the higher concentration of CO2 resulted in the low attention of students. However, the main problem in the classroom was overheating because of the big solar gain through the large south-oriented windows. The heating system was not regulated, which resulted in thermal discomfort in the classroom.
- -
- Secondly, a higher concentration of CO2 was found in the renovated classroom. The heating system was regulated, so interior overheating was eliminated. The windows were opened occasionally.
3.2. Results of Microbial Testing
4. Conclusions
Author Contributions
Funding
Institutional Review Board Statement
Informed Consent Statement
Acknowledgments
Conflicts of Interest
References
- Kubba, S. Indoor Environmental Quality. In Handbook of Green Building Design and Construction, 2nd ed.; Butterworth-Heinemann, Elsevier: Oxford, UK, 2017. [Google Scholar]
- Nowak, K.; Nowak-Dzieszko, K.; Marcinowski, A. Analysis of ventilation air exchange rate and indoor air quality in the office room using metabolically generated CO2. In IOP Conference Series, Proceedings of the Materials Science and Engineering, XIII International Research-Technical Conference on the Problems of Designing, Construction and Use of Low Energy Housing, Krakow, Poland, 11–13 September 2018; IOP Publishing: Bristol, UK, 2018; Volume 415, p. 012028. [Google Scholar]
- Redlich, C.A.; Sparer, J.; Cullen, M.R. Sick-building syndrome. Lancet 1997, 349, 1013–1016. [Google Scholar] [CrossRef]
- Fisk, W.J.; Mirer, A.G.; Mendell, M.J. Quantitative relationship of sick building syndrome symptoms with ventilation rates. Indoor Air 2009, 19, 159–165. [Google Scholar] [CrossRef] [PubMed]
- Finnegan, M.J.; Pickering, C.A.; Burge, P.S. The sick building syndrome: Prevalence studies. Br. Med. J. 1984, 289, 1573–1575. [Google Scholar] [CrossRef] [PubMed]
- Satish, U.; Mendell, M.J.; Shekhar, K.; Hotchi, T.; Sullivan, D.; Streufert, S.; Fisk, W.J. Is CO2 an Indoor Pollutant? Direct Effects of Low-to-Moderate CO2 Concentrations on Human Decision-Making Performance. Environ. Health Perspect. 2012, 120, 1671–1677. [Google Scholar] [CrossRef]
- Clements-Croome, D.J.; Awbi, H.B.; Bakó-Biró, Z.; Kochhar, N.; Williams, M. Ventilation rates in schools. Build. Environ. 2008, 43, 362–367. [Google Scholar] [CrossRef]
- Coley, D.A.; Beisteiner, A. Carbon Dioxide Levels and Ventilation Rates in Schools. Int. J. Vent. 2002, 1, 45–52. [Google Scholar] [CrossRef]
- Aversa, P.; Settimo, G.; Gorgoglione, M.; Bucci, E.; Padula, G.; de Marco, A. Case study of indoor air quality in a classroom by comparing passive and continuous monitoring. Environ. Eng. Manag. J. 2019, 18, 2107–2115. [Google Scholar]
- Wargocki, P.; Wyon, D.P. Ten questions concerning thermal and indoor air quality effects on the performance of office work and schoolwork. Build. Environ. 2017, 112, 359–366. [Google Scholar] [CrossRef]
- Pacitto, A.; Amato, F.; Moreno, T.; Pandolfi, M.; Fonseca, A.; Mazaheri, M.; Stabile, L.; Buonanno, G.; Querol, X. Effect of ventilation strategies and air purifiers on the children’s exposure to airborne particles and gaseous pollutants in school gyms. Sci. Total Environ. 2020, 712, 135673. [Google Scholar] [CrossRef]
- Becker, R.; Goldberger, I.; Paciuk, M. Improving energy performance of school buildings while ensuring indoor air quality ventilation. Build. Environ. 2007, 42, 3261–3276. [Google Scholar] [CrossRef]
- Settimo, G.; Indinnimeo, L.; Inglessis, M.; De Felice, M.; Morlino, R.; di Coste, A.; Fratianni, A.; Avino, P. Indoor Air Quality Levels in Schools: Role of Student Activities and No Activities. Int. J. Environ. Res. Public Health 2020, 17, 6695. [Google Scholar] [CrossRef]
- Kovesi, T.; Gilbert, N.L.; Stocco, C.; Fugler, D.; Dales, R.E.; Guay, M.; Miller, J.D. Indoor air quality and the risk of lower respiratory tract infections in young Canadian Inuit children. Can. Med. Assoc. J. 2007, 177, 155–160. [Google Scholar] [CrossRef]
- Carreiro-Martins, P.; Papoila, A.L.; Caires, I.; Azevedo, S.; Cano, M.M.; Virella, D.; Leiria-Pinto, P.; Teixeira, J.P.; Rosado-Pinto, J.; Annesi-Maesano, I.; et al. Effect of indoor air quality of day care centers in children with different predisposition for asthma. Pediatr. Allergy Immunol. 2016, 27, 299–306. [Google Scholar] [CrossRef]
- Mendell, M.J.; Heath, G.A. Do indoor pollutants and thermal conditions in schools influence student performance? A critical review of the literature. Indoor Air 2005, 15, 27–52. [Google Scholar] [CrossRef]
- Mendell, M.J.; Eliseeva, E.A.; Davies, M.M.; Lobscheid, A. Do classroom ventilation rates in California elementary schools influence standardized test scores? Results from a prospective study. Indoor Air 2016, 26, 546–557. [Google Scholar] [CrossRef] [PubMed]
- Coley, D.A.; Greeves, R.; Saxby, B.K. The Effect of Low Ventilation Rates on the Cognitive Function of a Primary School Class. Int. J. Vent. 2007, 6, 107–112. [Google Scholar] [CrossRef]
- Barrett, P.; Davies, F.; Zhaung, Y.; Barrett, L. The impact of classroom design on pupils’ learning: Final results of a holistic, multi-level analysis. Build. Environ. 2015, 89, 118–133. [Google Scholar] [CrossRef]
- Petersen, S.; Jensen, K.L.; Pedersen, A.L.S.; Rasmussen, H.S. The effect of increased classroom ventilation rate indicated by reduced CO2 concentration on the performance of schoolwork by children. Indoor Air 2016, 26, 366–379. [Google Scholar] [CrossRef] [PubMed]
- Bakó-Biró, Z.; Clements-Croome, D.; Kochhar, N.; Williams, M.J. Ventilation rates in schools and pupils’ performance. Build. Environ. 2012, 48, 215–223. [Google Scholar] [CrossRef]
- Iddon, C.R.; Huddleston, N. Poor indoor air quality measured in UK classrooms, increasing the risk of reduced pupil academic performance and health. In Proceedings of the International Indoor Air Conference, Hong Kong, China, 7–12 July 2014. [Google Scholar]
- Kalamees, T.; Väli, A.; Kallavus, U.; Kurik, L.; Alev, Ü. Simulated Influence of Indoor Climate and Ventilation on Schoolwork Performance in Estonian Manor Schools. Int. J. Vent. 2015, 14, 153–164. [Google Scholar] [CrossRef]
- Toftum, J.; Kjeldsen, B.U.; Wargocki, P.; Menå, H.R.; Hansen, E.M.N.; Clausen, G. Association between classroom ventilation mode and learning outcome in Danish schools. Build. Environ. 2015, 92, 494–503. [Google Scholar] [CrossRef]
- Haverinen-Shaughnessy, U.; Moschandreas, D.J.; Shaughnessy, R.J. Association between substandard classroom ventilation rates and students’ academic achievement. Indoor Air 2011, 21, 121–131. [Google Scholar] [CrossRef] [PubMed]
- Mendell, M.J.; Eliseeva, E.A.; Davies, M.M.; Spears, M.; Lobscheid, A.; Fisk, W.J.; Apte, M.G. Association of classroom ventilation with reduced illness absence: A prospective study in California elementary schools. Indoor Air 2013, 23, 515–528. [Google Scholar] [CrossRef]
- Haverinen-Shaughnessy, U.; Shaughnessy, R.J.; Cole, G.; Toyinbo, O.; Moschandreas, D.J. An assessment of indoor environmental quality in schools and its association with health and performance. Build. Environ. 2015, 93, 35–40. [Google Scholar] [CrossRef]
- Montazami, A.; Gaterell, M.; Nicol, F. A comprehensive review of environmental design in UK schools: History, conflicts and solutions. Renew. Sustain. Energy Rev. 2015, 46, 249–264. [Google Scholar] [CrossRef]
- Wargocki, P.; Wyon, D. Research report on effects of HVAC on student performance. Am. Soc. Heat Refrig. Air-Cond. Eng. (Ashrae) J. 2016, 48, 23–28. [Google Scholar]
- Heebøll, A.; Wargocki, P.; Toftum, J. Window and door opening behavior, carbon dioxide concentration, temperature, and energy use during the heating season in classrooms with different ventilation retrofits-ASHRAE RP1624. Sci. Technol. Built Environ. 2018, 24, 626–637. [Google Scholar] [CrossRef]
- Gil-Baez, M.; Barrios-Padura, A.; Molina-Huelva, M.; Chacartegui, R. Natural ventilation systems in 21st-century for near zero energy school buildings. Energy 2017, 137, 1186–1200. [Google Scholar] [CrossRef]
- Stabile, L.; Dell’Isola, M.; Russi, A.; Massimo, A.; Buonanno, G. The effect of natural ventilation strategy on indoor air quality in schools. Sci. Total Environ. 2017, 595, 894–902. [Google Scholar] [CrossRef]
- Jones, B.M.; Kirby, R. Indoor Air Quality in U.K. School Classrooms Ventilated by Natural Ventilation Windcatchers. Int. J. Vent. 2012, 10, 323–338. [Google Scholar] [CrossRef]
- Stabile, L.; Dell’Isola, M.; Frattolillo, A.; Massimo, A.; Russi, A. Effect of natural ventilation and manual airing on indoor air quality in naturally ventilated Italian classrooms. Build. Environ. 2016, 98, 180–189. [Google Scholar] [CrossRef]
- Duarte, R.; Gomez, M.G.; Rodrigez, A.M. Classroom ventilation with manual opening of windows: Findings from a two-year-long experimental study of a Portuguese secondary school. Build. Environ. 2017, 124, 118–129. [Google Scholar] [CrossRef]
- Angelopoulos, C.; Cook, M.J.; Iddon, C.R.; Porritt, S.M. Evaluation of thermal comfort in naturally ventilated school classrooms using CFD. In Proceedings of the 15th Conference of International Building Performance Simulation Association, San Francisco, CA, USA, 7–9 August 2017. [Google Scholar]
- Applications Manual AM 10. Natural Ventilation in Non-domestic Buildings; CIBSE: London, UK, 2005; ISBN 9781903287569. [Google Scholar]
- Chartered Institution of Building Services Engineers (CIBSE). CIBSE TM57 Integrated School Design; CIBSE: London, UK, 2015. [Google Scholar]
- Guidance BB101 Ventilation, Thermal Comfort and Indoor Air Quality in Schools; Education & Skills Funding Agency: Coventry, UK, 2018.
- Griffiths, M.; Eftekhari, M. Control of CO2 in a naturally ventilated classroom. Energy Build. 2008, 40, 556–560. [Google Scholar] [CrossRef]
- Project Sinphonie, Final Report 2014. Available online: https://publications.jrc.ec.europa.eu/repository/bitstream/JRC91160/lbna26738enn.pdf (accessed on 15 December 2020).
- Guidelines for Healthy Indoor Environments within European Schools. Available online: https://ec.europa.eu/jrc/en/publication/eur-scientific-and-technical-research-reports/guidelines-healthy-environments-within-european-schools (accessed on 15 December 2020).
- WHO. WHO Guidelines for Indoor Air Quality: Dampness and Mould; World Health Organisation: Copenhagen, Denmark, 2009. [Google Scholar]
- Nevalainen., A.; Täubel, M.; Hyvärinen, A. Indoor fungi: Companions and contaminants. Indoor Air 2015, 25, 125–156. [Google Scholar] [CrossRef]
- Dudzinska, M.R. (Ed.) Management of Indoor Air Quality; CRC Press, Taylor and Francis: London, UK, 2011. [Google Scholar]
- Linda, D.; Stetzenbach, A.H.; Johanning, E.; King, G.; Shaughnessy, R.J. Microorganisms, Mold and Indoor Air Quality. Americal Society for Microbiology, 2004. Available online: https://asm.org/ASM/media/docs/Iaq.pdf (accessed on 12 March 2021).
- Brandys, R.C.; Brandys, G.M. Worldwide Exposure Standards for Mold and Bacteria—Historical and Current Perspectives; Occupational & Environmental Health Consulting Services Inc. OEHCS: Hinsdale, IL, USA, 2005. [Google Scholar]
- Pasanen, A.L.; Kalliokioski, O.; Pasanen, P.; Jantunen, M.J.; Nevalainen, A. Laboratory studies on the relationship between fungal growth and atmospheric temperature and humidity. Environ. Int. 1991, 17, 225–228. [Google Scholar] [CrossRef]
- Oxkten, S.; Ahmet, A. Airborne fungi and bacteria in indoor and outdoor environment of the Pediatric Unit of Edirne. Environ. Monit. Assess. 2012, 184, 1739–1751. [Google Scholar] [CrossRef] [PubMed]
- Mendell, M.J.; Mirer, A.G.; Cheung, K.; Tong, M.; Douwes, J. Respiratory and allergic health effect of dampness, mold, and dampness-related agents: A review of the epidemiologic evidence. Environ. Health Perspect. 2011, 119, 748–756. [Google Scholar] [CrossRef]
- Ege, M.J.; Mayer, M.; Normand, A.C.; Genuneit, J.; Cookson, W.O.; Braun-Fahrländer, C.; Heederik, D.; Piarroux, R.; von Mutius, E. Exposure to environmental microorganisms and childhood asthma. N. Engl. J. Med. 2011, 364, 701–709. [Google Scholar] [CrossRef]
- Hospodsky, D.; Yamamoto, N.; Nazaroff, W.W.; Miller, D.; Gorthala, S.; Peccia, J. Characterizing airborne fungal and bacterial concentrations and emission rates in six occupied children’s classrooms. Indoor Air 2014, 25, 641–652. [Google Scholar] [CrossRef]
- Aydogdu, H.; Asan, A.; Otkun, M.T.; Ture, M. Monitoring of Fungi and Bacteria in the Indoor Air of Primary Schools in Edirne City, Turkey. Indoor Built Environ. 2005, 14, 411–425. [Google Scholar] [CrossRef]
- Kleinheinz, G.T.; Campbell, A. Seasonal Impacts on Indoor Fungal Concentrations after Mold Remediation. Sdrp J. Earth Sci. Environ. Stud. 2017, 2, 135–145. [Google Scholar]
- GPS Coordinates. Available online: https://www.gps-coordinates.net (accessed on 2 December 2020).
- Simoni, M.; Annesi-Maesano, I.; Sigsgaard, T.; Norback, D.; Wieslander, G.; Nystad, W.; Canciani, M.; Sestini, P.; Viegi, G. School air quality related to dry cough, rhinitis and nasal patency in children. Eur. Respir. J. 2010, 35, 742–749. [Google Scholar] [CrossRef] [PubMed]
- Standard BS EN ISO 4833-2:2013. Microbiology of the Food Chain. Horizontal Method for the Enumeration of Microorganisms; Colony Count at 30 Degrees C by the Surface Plating Technique; British Standards Institution: London, UK, 2013. [Google Scholar]
- Wanner, H.U.; Verhoeff, A.; Colombi, A.; Flannigan, B.; Gravesen, S.; Mouilleseaux, A.; Nevalainen, A.; Papadakis, J.; Seidel, K. Biological Particles in Indoor Environment. EUR 14988—European Collaborative Action Indoor Air Quality and Its Impact on Man. Report No.12. 1993. Available online: https://www.aivc.org/resource/eca-12-biological-particles-indoor-environments (accessed on 15 December 2020).
- Gładyszewska-Fiedoruk, K.; Zhelykh, V.; Pushchinskyi, A. Simulation and Analysis of Various Ventilation Systems Given in an Example in the Same School of Indoor Air Quality. Energies 2019, 12, 2845. [Google Scholar] [CrossRef]

| Concentration | Bacteria (CFU/m3) | Fungi (CFU/m3) | |
|---|---|---|---|
| Category | Very low | <50 | <25 |
| Low | <100 | <100 | |
| Medium | <500 | <500 | |
| High | <2000 | <2000 | |
| Very high | >2000 | >2000 | |
| Sample | Surface, Position in the Room | Sample Surface Area | Number of Microorganisms in Colony-Forming Units (CFU) in 50 mL | ||
|---|---|---|---|---|---|
| Total Number of Microorganisms | Micromicets | ||||
| Yeast Cells | Fungi | ||||
| 1 | Wooden desk, middle of the room | 0.6 m × 0.45 m | 95,033 | Not detected | 926 |
| 2 | Wooden desk, near the central window | 0.6 m × 0.45 m | 112,626 | Not detected | 1111 |
| 3 | Wooden desk, near the opposite wall | 0.6 m × 0.45 m | 411,544 | 9511 | 185 |
| 4 | Wooden desk, near the front window | 0.6 m × 0.45 m | 67,656 | 185 | 93 |
| 5 | PVC floor finishing, under the blackboard | 0.15 m × 0.60 m | 344,444 | 3033 | 12,889 |
| 6 | PVC floor finishing, under the white board | 0.15 m × 0.60 m | 57,033 | Not detected | 1111 |
| 7 | Plaster, wall with the boards | 0.20 m × 0.30 m | 4717 | Not detected | 417 |
| 8 | Plaster, wall opposite windows | 0.20 m × 0.30 m | 6117 | 417 | 417 |
Publisher’s Note: MDPI stays neutral with regard to jurisdictional claims in published maps and institutional affiliations. |
© 2021 by the authors. Licensee MDPI, Basel, Switzerland. This article is an open access article distributed under the terms and conditions of the Creative Commons Attribution (CC BY) license (https://creativecommons.org/licenses/by/4.0/).
Share and Cite
Mocová, P.; Mohelníková, J. Indoor Climate Performance in a Renovated School Building. Energies 2021, 14, 2827. https://doi.org/10.3390/en14102827
Mocová P, Mohelníková J. Indoor Climate Performance in a Renovated School Building. Energies. 2021; 14(10):2827. https://doi.org/10.3390/en14102827
Chicago/Turabian StyleMocová, Pavla, and Jitka Mohelníková. 2021. "Indoor Climate Performance in a Renovated School Building" Energies 14, no. 10: 2827. https://doi.org/10.3390/en14102827
APA StyleMocová, P., & Mohelníková, J. (2021). Indoor Climate Performance in a Renovated School Building. Energies, 14(10), 2827. https://doi.org/10.3390/en14102827

